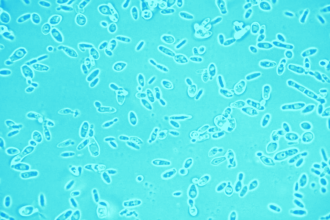

Two big trends are happening in wine right now. First, the 20s and 30s crowds are the largest wine drinking generation ever, and last year, millennials drank 44 percent of all the wine consumed in the US! Second, online wine sales are finally gaining traction. Over the last decade, as everything moved to being sold online in some fashion or another, wine was slow to the party. But that’s all starting to change.
Now that you can finally find wine online, you’d probably assume that it’s of the same solid quality as the kind you’d find at your trusted, local wine store – and a lot of it is! But part of this market has been taken up by what we call “bulk juice.”
The dirty little secret in the wine biz is that some companies import huge bladders of this unfinished wine to the US and sell it off as their own. By unfinished, we mean wine that is either yet to be aged, needs further aging or is drinkable but still in need of bottling and labeling. That juice can then be manipulated in several different ways, such as adding a sprinkle of oak dust here and a dash of extra Chardonnay there and you’ve got yourself what legally is considered to be a whole new wine blend! Now slap a fun label on that puppy and get it up on the website. Easy, right?
Now you may be asking, “Yeah, easy, what’s the big deal? There’s nothing wrong with buying things in bulk, that’s what makes Costco so damn awesome!” Well the big deal, in our humble opinion, is that wine isn’t your average product. Winemaking is an art form, and every bottle tells a story. Bulk buying wine to slightly manipulate it and dress it up in a pretty bottle is masking the story the wine is trying to tell the drink – and it can often be because the juice itself wasn’t all that great to begin with. This is doing a disservice to the wine industry and the wine drinker.
Wine is a romance product because it comes from a place, a year and a style. It is made by real people. And how the wine is made is important. Wine is art. As consumers, sometimes we just want a big, delicious glass at the end of a hard day without knowing varietals, vintages, and any fancy wine words. And that’s cool too. But why can’t you have it both ways? We at WA would never try to cover up a wine’s true identity – but we would collaborate with winemakers to bring you something awesome.
Which brings us to private labeling. Private labeling is when a winemaker crafts a vintage of wine and then sells it, either as a single varietal or as a blend unique to the collaborator. So while the wine is still produced by the winemaker, it’s bottled in collaboration with the brand who owns it. In this month’s box, we’re very excited to announce, we have introduced our first WA brand in collaboration with the acclaimed family winery, Carrier Wines.
Meet La Pinot. Born in 2013, it’s from the Santa Lucia Highlands of California, and it’s a Pinot Noir that tastes exactly like where it comes from. Wine geeks call this “terroir.” We just think the juice tastes damn good. The Caraccioli brothers are a real deal wine family and the WA Crew is crazy thrilled to have worked with them to create this label. You can find it in our subscription, on our wine list and in wine shops in NYC (more cities soon). I’d love to personally know what you think about our first partnership brand. Have thoughts? Email me at logan@wineawesomeness.com. For real.
Ready to snag your own bottle of La Pinot? Grab ’em before we drink them all ourselves.

The only problem is the “Pinot Noir” is a masculine noun, and the wine thereby should take the masculine prepostion “Le”, but whatever..
Agree with Dan King…but whatevahs as they say in Aiea, Hawaii